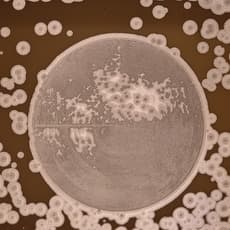
Pierre Cordier

Belgian Artists
260 artists from Belgian

Neoza Goffin
Ghent, Belgium

Noa Verkeyn
Antwerp, Belgium

Noro Khachatryan
Brussels, Belgium

Olivier Goethals
Ghent, Belgium

Paul-Auguste Masui
Luxembourgeois / Belgian

Paul Robbrecht
Belgian

Pawel Czermak
Antwerp

Peggy Wauters
Geraardsbergen, Belgium

Peter De Meyer
Antwerp, Belgium

Peter Morrens
Lier, Belgium

Peter Rogiers
Antwerp, Belgium

Philippe Van Snick
Brussels, Belgium

Pierre Bergian
Bruges, Belgium

Pierre Cordier
Brussels, Belgium
P
pierre gerard
Liège, Belgium

Pol Mara
Antwerp, Belgium

René Guiette
Antwerp, Belgium

Rob Buelens
Belgian

Roel D'Haese
Nieuwpoort, Belgium

Roger Dudant
Belgian

Roland Quetsch
Belgium

Ronny Delrue
Ghent, Belgium

Ruben Bellinkx
Brussels, Belgium
Rudolf Meerbergen
Belgian